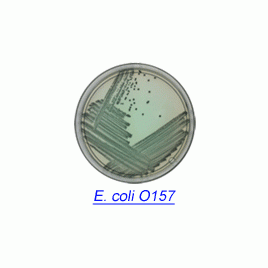

Product
제품
소개
Rainbow® Agar O157 (Dehydrated Media)
Chromogenic Media for Microbial Detection Less than 24 Hours
Rainbow Agar O157 has both selective and chromogenic properties that make it particularly useful for isolating pathogenic E. coli strains. The medium contains chromogenic substrates that are specific for two E. coli-associated enzymes: ßgalactosidase (a blue-black chromogenic substrate) and ß-glucuronidase (a red chromogenic substrate).
Rainbow Agar O157 is listed in FDA's Bacteriological Analytical Manual (BAM) and presents the agency's preferred laboratory procedures for microbiological analyses of foods and cosmetics.
EXPECTED RESULTS
Organism Colony Color
E. coli O157:H7 Black or gray
E. coli O157:H7 (glucuronidase+) Purple-blue
E. coli O26:H11 Purple magenta
E. coli O48:H21 Purple
E. coli O111:H or O111:H8 Violet or gray
주문정보
80102 Rainbow® Agar O157 30 g packet (approx. 25 plates)
관련자료